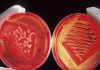
Ο λόγος που ο Candida Auris τρομάζει πολύ περισσότερο απ’ τον κορωνοϊό

Απίστευτες διαστάσεις λαμβάνει το πρόβλημα της στεγαστικής κρίσης στην Ελλάδα, με τις τιμές των ενοικίων να έχουν «ξεφύγει» τα τελευταία χρόνια και τους πολίτες να ψάχνουν για μήνες στέγη που μπορούν να καλύψουν οικονομικά.
Για μια σωρευτική αύξηση των τιμών από το 2018 έως και σήμερα που αγγίζει περίπου το 44,6% στην Αθήνα και 32% στη Θεσσαλονίκη, κάνει λόγο ο Θέμης Μπάκας, πρόεδρος του Πανελλαδικού Δικτύου E-Real Estates.
Μιλώντας στην ΕΡΤ για τους βασικούς λόγους αύξησης των τιμών των ακινήτων, ο κτηματομεσίτης σημείωσε ότι η κύρια αιτία είναι η αύξηση του κόστους κατασκευής.
«Είδαμε τα τελευταία δύο με τρία έτη ότι έχουμε αύξηση έως κατασκευής ακόμα και 20-25%. Μετά έχουμε την αύξηση τιμών πώλησης και τα ποσοστά αντιπαροχής των οικοπέδων», πρόσθεσε.
Αναφερόμενος στην υψηλή ζήτηση και τη μικρή διαθεσιμότητα για νεόδμητα ακίνητα τόνισε ότι το κόστος τους αυξάνει επίσης λόγω και του έντονου επενδυτικού ενδιαφέροντος.
«Βλέπετε ότι πάρα πολύ έντονα τα τελευταία τουλάχιστον 3 – 4 έτη είδαμε πάρα πολλούς αλλοδαπούς να μπαίνουν στη λογική να θέλουν να επενδύσουν στην ακίνητη περιουσία της χώρας μας και το ενδιαφέρον του επενδυτικού να είναι αμείωτο», συμπλήρωσε.
Πολλοί λίγοι Έλληνες έχουν αποταμιεύσεις για να πάρουν στεγαστικό δάνειο
Ένας ακόμα επιβαρυντικός παράγοντας για την αύξηση των ενοικίων είναι τα λιγοστά στεγαστικά δάνεια που εγκρίνονται γεγονός που σημαίνει ότι δεν κατασκευάζονται νέα, καθώς και το υψηλό ποσοστό προκαταβολής για την αγορά ενός σπιτιού που φτάνει ακόμα και το 30% σε σχέση με την εμπορική του αξία.
«Άρα ένα πολύ μικρό ποσοστό Ελλήνων καταθετών έχουν αποταμιεύσεις μετά από 10 χρόνια μνημόνια, έτσι ώστε να μπορούν να μπουν στη διαδικασία της αγοράς κατοικίας μέσω τραπεζικού δανεισμού» είπε και πρόσθεσε ότι «είδαμε τη μείωση οικοδομικής δραστηριότητας ακόμα και 95% τα χρόνια των μνημονίου».
Οι 9 + 1 λόγοι που αυξήθηκαν τα ενοίκια
- Η υποαπόδοση των προηγούμενων χρόνων
- Ο ρόλος των τραπεζών
- Μείωση της οικοδομικής δραστηριότητας
- Πλειστηριασμοί
- Μείωση της ιδιοκατοίκησης
- Συσσωρευμένη ζήτηση/ Μικρή διαθεσιμότητα
- Υποχώρηση της αγοραστικής δύναμης
- Εργασιακή ανασφάλεια
- Βραχυχρόνιες μισθώσεις
- Μη ύπαρξη ολοκληρωμένου σχεδίου στεγαστικής πολιτικής
Πηγή: dikaiologitika.gr